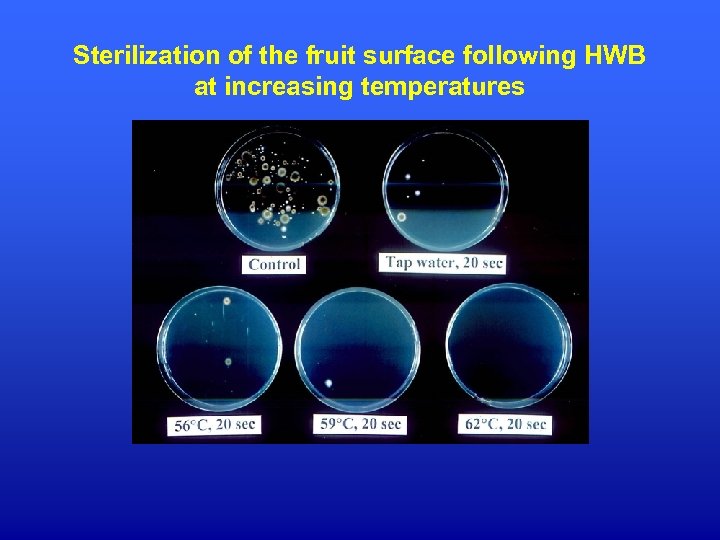
Sterilization of the fruit surface following HWB at increasing temperatures

f5b84e5dd81bf0081448e59e6245e1bc.ppt
- Количество слайдов: 28
 Postharvest Alternatives to Chemical Fungicides Dr. Ron Porat Dept. of Postharvest Science of Fresh Produce ARO, The Volcani Center, Bet Dagan, Israel
Postharvest Alternatives to Chemical Fungicides Dr. Ron Porat Dept. of Postharvest Science of Fresh Produce ARO, The Volcani Center, Bet Dagan, Israel
 Why do we need to search for alternative replacements for chemical fungicides? Health concerns regarding fungicide toxicity resulted in public demand for chemical-free products. New regulations and restricted residue limits. Development of pathogenic strains resistance to current used fungicides. Difficulties in registration of new fungicides.
Why do we need to search for alternative replacements for chemical fungicides? Health concerns regarding fungicide toxicity resulted in public demand for chemical-free products. New regulations and restricted residue limits. Development of pathogenic strains resistance to current used fungicides. Difficulties in registration of new fungicides.
 A picture of the show window of a major coffee shop in England
A picture of the show window of a major coffee shop in England
 Postharvest alternatives to chemical fungicides Physical treatments (heat, UV). Biological control. Safe chemicals (GRAS) (soda, calcium, oils). Induction of pathogen resistance. Combination of various alternative treatments.
Postharvest alternatives to chemical fungicides Physical treatments (heat, UV). Biological control. Safe chemicals (GRAS) (soda, calcium, oils). Induction of pathogen resistance. Combination of various alternative treatments.
 Physical treatments UV irradiation Several studies showed that low dose UV irradiation can disinfect the commodity and enhance pathogen resistance.
Physical treatments UV irradiation Several studies showed that low dose UV irradiation can disinfect the commodity and enhance pathogen resistance.
 Drawbacks in the use of UV irradiation: 1. Low doses do not eradicate all pathogens. 2. High doses cause injuries and increase decay. 3. Fruit tolerance to UV changes during the season. 4. Consumers do not want “irradiated” produce. Overall, although many studies, especially during the late 80’s and early 90’s, UV irradiation did not become a popular commercial postharvest treatment!
Drawbacks in the use of UV irradiation: 1. Low doses do not eradicate all pathogens. 2. High doses cause injuries and increase decay. 3. Fruit tolerance to UV changes during the season. 4. Consumers do not want “irradiated” produce. Overall, although many studies, especially during the late 80’s and early 90’s, UV irradiation did not become a popular commercial postharvest treatment!
 Heat treatments Hot air – holding the fruit for 2 -4 days at ~38 C. This treatment allows healing (curing) of the wounds, while it arrests pathogen development. Hot water - dipping or rinsing the fruit with hot water. The hot water treatment disinfects the produce without causing heat damage.
Heat treatments Hot air – holding the fruit for 2 -4 days at ~38 C. This treatment allows healing (curing) of the wounds, while it arrests pathogen development. Hot water - dipping or rinsing the fruit with hot water. The hot water treatment disinfects the produce without causing heat damage.
 Effects of hot water on P. digitatum spore germination
Effects of hot water on P. digitatum spore germination
 Many studies showed that hot water dips (2 -3 min at 53ºC) reduces decay development. Recently, a new method combining a short hot water rinsing and brushing treatment (55 -60ºC for 20 -30 s) was developed to clean and disinfect agricultural products.
Many studies showed that hot water dips (2 -3 min at 53ºC) reduces decay development. Recently, a new method combining a short hot water rinsing and brushing treatment (55 -60ºC for 20 -30 s) was developed to clean and disinfect agricultural products.
 Hot water rinsing and brushing of citrus fruit Advantages 1. HWB cleans the fruit 2. HWB removes and kills surface pathogens 3. HWB smoothens wax surface and seals wounds and cracks 4. HWB induces pathogen and chilling resistance 5. HWB is part of the packinghouse sorting line
Hot water rinsing and brushing of citrus fruit Advantages 1. HWB cleans the fruit 2. HWB removes and kills surface pathogens 3. HWB smoothens wax surface and seals wounds and cracks 4. HWB induces pathogen and chilling resistance 5. HWB is part of the packinghouse sorting line
 ‘Star Ruby’ grapefruit before and after hot water brushing
‘Star Ruby’ grapefruit before and after hot water brushing
Sterilization of the fruit surface following HWB at increasing temperatures
Sterilization of the fruit surface following HWB at increasing temperatures
 Effects of HWB on fruit wax surface Control HWB
Effects of HWB on fruit wax surface Control HWB
 Induction of grapefruit resistance against P. digitatum by HWB treatments Fruit were inoculated 24 h after the heat treatment
Induction of grapefruit resistance against P. digitatum by HWB treatments Fruit were inoculated 24 h after the heat treatment
 Summary HWB has many advantages: it cleans the fruit, disinfects it from surface pathogens and is built as part of the packinghouse sorting line. HWB has a major disadvantage as a replacement of fungicides: It doesn’t have any residual effect. Therefore, it can sterilize the fruit surface but can’t protect from later infection during storage and shelf-life.
Summary HWB has many advantages: it cleans the fruit, disinfects it from surface pathogens and is built as part of the packinghouse sorting line. HWB has a major disadvantage as a replacement of fungicides: It doesn’t have any residual effect. Therefore, it can sterilize the fruit surface but can’t protect from later infection during storage and shelf-life.
 Biological control comprises using natural occurring microorganisms to compete with the pathogens. Modes of action of biocontrol antagonists 1. Competition on space and nutrients. 2. Production of antibiotics 3. Direct parasitism 4. Induction of host pathogen resistance
Biological control comprises using natural occurring microorganisms to compete with the pathogens. Modes of action of biocontrol antagonists 1. Competition on space and nutrients. 2. Production of antibiotics 3. Direct parasitism 4. Induction of host pathogen resistance
 Mode of action of biocontrol antagonists Colonization in wound sites (competition on space) Attachment to fungal cell walls (direct parasitism)
Mode of action of biocontrol antagonists Colonization in wound sites (competition on space) Attachment to fungal cell walls (direct parasitism)

 Commercial biocontrol products available for postharvest use
Commercial biocontrol products available for postharvest use
 Experimental Biocontrol Products Shemer - Bayer Microflo
Experimental Biocontrol Products Shemer - Bayer Microflo
 Summary Advantages of biocontrol: 1. Environmental safety. 2. Quite effectively reduces the development of some diseases. Disadvantages if biocontrol: 1. Not as effective as chemical fungicides. 2. Can not kill the pathogen, and therefore can not protect from already existing infections but only from later infections. 3. Its effectiveness is inconsistent.
Summary Advantages of biocontrol: 1. Environmental safety. 2. Quite effectively reduces the development of some diseases. Disadvantages if biocontrol: 1. Not as effective as chemical fungicides. 2. Can not kill the pathogen, and therefore can not protect from already existing infections but only from later infections. 3. Its effectiveness is inconsistent.
 Safe chemicals (GRAS) The idea is to apply safe edible compounds also known as “food additives” like baking soda, calcium salts, ethanol and various oils that persist antifungal activity to inhibit pathogen growth. Vacuum infiltration of calcium ions strengthens the cell walls and reduces decay in apples. Application of sodium carbonate (soda ash) and sodium bicarbonate (baking soda) reduces decay in citrus. Application of ethanol reduced decay in grapes. The problem is that food additives are not such effective as chemical fungicides in reducing decay development!
Safe chemicals (GRAS) The idea is to apply safe edible compounds also known as “food additives” like baking soda, calcium salts, ethanol and various oils that persist antifungal activity to inhibit pathogen growth. Vacuum infiltration of calcium ions strengthens the cell walls and reduces decay in apples. Application of sodium carbonate (soda ash) and sodium bicarbonate (baking soda) reduces decay in citrus. Application of ethanol reduced decay in grapes. The problem is that food additives are not such effective as chemical fungicides in reducing decay development!
 Induction of host disease resistance The idea is instead of applying toxic fungicides to “kill” the pathogens to treat the commodity with various elicitors that increase tolerance against pathogen infection. For example, it is known that various compounds, such as jasmonic acid and salicylic acid, and environmental conditions like UV irradiation and heat can increase pathogen resistance. Currently, there a few commercial compound (“Bion”, “Messenger”) that are used to increase pathogen resistance. However, there effectiveness in postharvest use is yet questionable.
Induction of host disease resistance The idea is instead of applying toxic fungicides to “kill” the pathogens to treat the commodity with various elicitors that increase tolerance against pathogen infection. For example, it is known that various compounds, such as jasmonic acid and salicylic acid, and environmental conditions like UV irradiation and heat can increase pathogen resistance. Currently, there a few commercial compound (“Bion”, “Messenger”) that are used to increase pathogen resistance. However, there effectiveness in postharvest use is yet questionable.
 Integrative control of postharvest diseases by combination of alternative treatments Some alternative treatments have sanitizing effects but do not persist further protective activity (hot water, UV). Other treatments, have protective activity but do not have curative activity and can not disinfect already existing infections (biocontrol agents). Some treatments persist both curative and protective activity (soda). By combining various treatment together, it is possible to achieve both curative and protecting activity, and to improve the efficacy of decay reduction.
Integrative control of postharvest diseases by combination of alternative treatments Some alternative treatments have sanitizing effects but do not persist further protective activity (hot water, UV). Other treatments, have protective activity but do not have curative activity and can not disinfect already existing infections (biocontrol agents). Some treatments persist both curative and protective activity (soda). By combining various treatment together, it is possible to achieve both curative and protecting activity, and to improve the efficacy of decay reduction.
 100 90 80 70 60 50 40 30 20 10 0 So da W B +y ea H st W B +s od So a da H W +y B ea +s st od a+ ye as t H t Ye as B W H ro l Curative effect on t C Decay (%) Integrated Control of Postharvest Decay on Red Grapefruit (inoculated fruit)
100 90 80 70 60 50 40 30 20 10 0 So da W B +y ea H st W B +s od So a da H W +y B ea +s st od a+ ye as t H t Ye as B W H ro l Curative effect on t C Decay (%) Integrated Control of Postharvest Decay on Red Grapefruit (inoculated fruit)
 al il az Im ea st So da +y a +s od W B W H H on t ro l B +y ea st 12 11 10 9 8 7 6 5 4 3 2 1 0 C Decay (%) Integrated Control of Postharvest Decay on Red Grapefruit (Natural infection during storage)
al il az Im ea st So da +y a +s od W B W H H on t ro l B +y ea st 12 11 10 9 8 7 6 5 4 3 2 1 0 C Decay (%) Integrated Control of Postharvest Decay on Red Grapefruit (Natural infection during storage)
 Summary By combining two or three different alternative postharvest treatments with different modes of action (curative and protective activity), it is possible to reduce decay development almost as well as chemical fungicides do!
Summary By combining two or three different alternative postharvest treatments with different modes of action (curative and protective activity), it is possible to reduce decay development almost as well as chemical fungicides do!
 Thank you for your attention!
Thank you for your attention!


